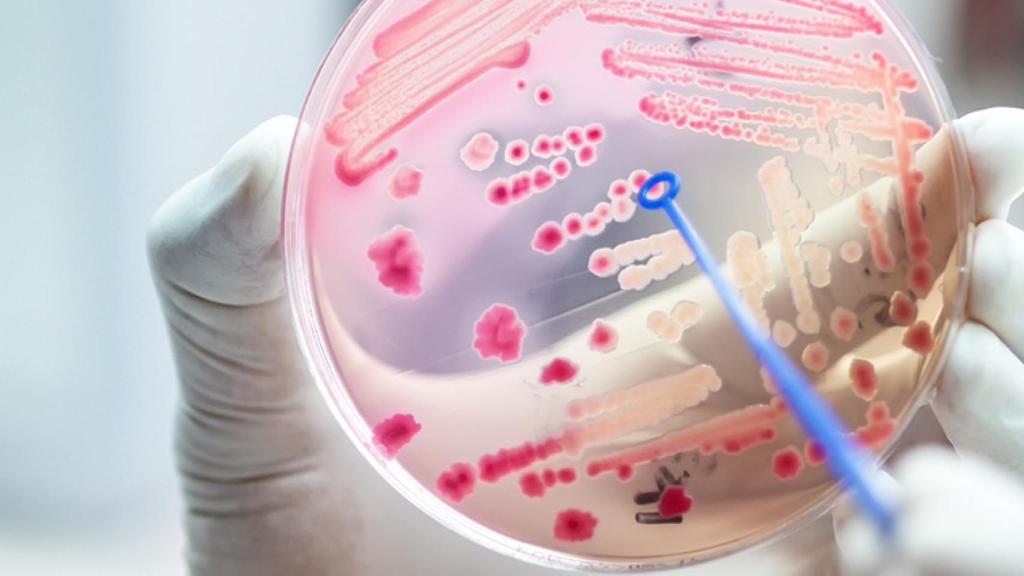
Una placa de Petri con un cultivo de bacterias intestinales.

Una placa de Petri con un cultivo de bacterias intestinales.
Golpe a la depresión: identifican 13 bacterias intestinales relacionadas con el trastorno mental
Algunos estudios ya habían establecido una conexión entre el microbioma y algunos síntomas de depresión y ahora dos nuevos trabajos la confirman.
La depresión es uno de los trastornos mentales que, por desgracia, están más presentes en nuestro día a día. Sin embargo, todavía sigue siendo una gran desconocida y, por eso, los investigadores siguen buscando pistas sobre su funcionamiento más allá del cerebro. Uno de los lugares más prometedores donde los científicos están encontrando nueva información es el intestino. Algunos estudios han indicado que las bacterias presentes en este órgano tienen cierto papel en los síntomas de esta patología y, en este sentido, se acaban de publicar dos nuevos estudios en Nature Communications.
En concreto, estos dos estudios han encontrado unas bacterias intestinales específicas que son responsables de la síntesis de mensajeros químicos clave de la depresión. Además, el estudio ha observado las diferencias y las similitudes en este aspecto entre diferentes etnias. Este abordaje es especialmente interesante porque tanto el microbioma como los niveles de síntomas depresivos varían de manera sustancial entre grupos étnicos. En todo caso, estos mecanismos biológicos de la microbiota están todavía poco estudiados.
"Este es un tema muy interesante y en plena progresión", explica Eduard Vieta, director científico del Centro de Investigación Biomédica en Red de Salud Mental (Cibersam) a Science Media Center (SMC). "Los resultados no son extremadamente novedosos (sólo en una pequeña parte), pero confirman los cambios en el microbioma ya descritos y lo hacen en una muestra de las más amplias hasta la fecha. Además, lo hacen midiendo la gravedad de los síntomas depresivos y controlando por la coexistencia de otras patologías y los efectos del tratamiento".
Grandes muestras
Precisamente, los expertos han destacado que uno de los principales puntos fuertes de estos estudios son las muestras analizadas. En ambos estudios se estudió el microbioma fecal como representante del microbioma intestinal. El primero de ellos fue dirigido por Jos Bosch, de la Universidad de Ámsterdam, y estudió el microbioma de 3.211 personas que se encuentran recogidos en una cohorte del estudio HELIUS. La ventaja de esta cohorte es que en ella participan personas de hasta seis grupos étnicos residentes en la capital de los Países Bajos: holandeses, surinameses del sur de Asia, surinameses africanos, ghaneses, turcos y marroquíes.
Los datos de la microbiota intestinal de estos participantes fueron vinculados a datos demográficos, conductuales y de depresión y, de esta manera, los científicos lograron dar con una firma microbiana predictiva para síntomas depresivos. Además, esta firma era invariable en gran medida entre los grupos étnicos observados. El otro estudio estuvo dirigido por dos investigadores: Robert Kraaij, del Erasmus Medical Center en Rotterdam (Países Bajos), y Najaf Amin, de la Universidad de Oxford (Reino Unido).
[Golpe español a la depresión: este es el aminoácido que aumenta el riesgo de sufrirla]
En este caso, los autores del estudio pudieron analizar la microbiota intestinal de 1.054 participantes, que compararon con una muestra conocida como la Cohorte de Rotterdam. Gracias a este proceso lograron encontrar 13 taxones microbianos asociados con los síntomas de depresión como Eggerthella, Subdoligranulum y Coprococcus. Después, estos hallazgos se replicaron usando la cohorte del estudio HELIUS. Los autores descubrieron que estas bacterias están involucradas en la síntesis de mensajeros químicos que ya se habían vinculado anteriormente a la depresión: glutamato, butirato, serotonina y ácido gamma amino butírico (GABA).
Un paso adelante
"La implicación que tienen estos trabajos es que debemos añadir la microbiota intestinal como un factor más en la causa de la depresión", explica Rosa del Campo, investigadora en el Hospital Ramón y Cajal y miembro del Grupo Especializado para el Estudio de la Microbiota Humana de la Sociedad Española de Enfermedades Infecciosas y Microbiología Clínica (SEIMC-Gembiota). "Se sugiere que es una causa orgánica relacionada con la producción/degradación de neurotransmisores por parte de las bacterias del tránsito intestinal. Por el momento no podemos utilizar antibióticos por la alta presión de resistencia, los probióticos tienen una utilidad dudosa y el trasplante fecal no está autorizado para este tipo de patologías".
[Depresión: hallan la primera evidencia directa en décadas de su vínculo con la serotonina baja]
De todas formas, aunque este estudio marca un paso adelante en el conocimiento sobre esta relación entre el intestino y la depresión, algunos expertos han destacado que contiene algunas limitaciones: "La principal limitación de estos dos estudios es que solo caracterizan el ecosistema bacteriano analizando una porción muy reducida del genoma bacteriano que es altamente variable y sirve para atribuir la taxonomía en lugar de secuenciar todo el ADN bacteriano. De esta forma, sólo pueden describir familias o, a lo sumo, géneros de bacterias asociados a síntomas depresivos", razona José Manuel Fernández-Real, jefe del grupo de Nutrición, Eumetabolismo y Salud del Idibgi y del Ciberobn.
"Estos resultados suponen un paso adelante en la comprensión de los cambios inflamatorios asociados a la depresión y de la conexión entre nuestra flora digestiva y el funcionamiento cerebral", resume Vieta. "Todavía es muy pronto para hablar de tratamientos. Por una parte, hay indicios de que una dieta equilibrada puede mejorar la salud mental, aunque no es un tratamiento adecuado por sí solo para la depresión mayor. Por otra parte, sería prematuro y fantasioso plantearse a día de hoy el trasplante fecal como una alternativa terapéutica".




